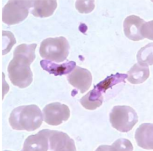
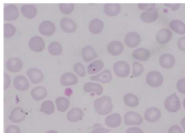

Malaria and Filariasis
1/49
There's no tags or description
Looks like no tags are added yet.
Name | Mastery | Learn | Test | Matching | Spaced |
|---|
No study sessions yet.
50 Terms
What is the pre patent period
Time from inoculation of sporozoite until parasites are detected by microscopy of blood
What is incubation period
Time from inoculation of sporozoits until a person develops clinical signs
What is relapse
New brood of parasites from hypnozoites in liver
What is recrudesence
Undetectable blood stage infection caused by drug resistance, unusual pharmacokinetics or incomplete dose
What is reinfection
Caused by new exposure
What is unstable malaria
Seasonal transmission
Plasmodium falciparum incubation period
9-14 day
Plasmodium vivax incubation period
12-17 day
Plasmodium malariae incubation period
18-40 day
Plasmodium ovale incubation period
16-18 day
Plasmodium knowlesi incubation period
9-12 day
Which plasmodium species has the shortest intra-erythrocytic cycle
24 hours; P knowlesi
How is P. knowlesi diagnosed
PCR ONLY
Malaria life cycle
Schizogony: Sporozoite replicate in hepatocyte → Merozoite enter RBC (symptom stage) → Ring stage (early trophozoite) → trophozoite → Schizont → Schizont break into merozoite → spread into blood
How does malaria cause fever
Malaria toxin in blood → Burst of TNF alpha by activated M → Fever = overproduction of TNF a
TNF a toxicity also causes what symptoms
Nausea, muscle pain, headache, loss of appetite
How does malaria affect liver
Sporozoite invade hepatocyte → Kupffer cells accumulate hemozoin pigment → Reduction of phagocytic ability → Kupffer loss of function
Malaria in the spleen
Anemia from destroyed RBC → Splenomegaly from increased RBC formation
Malaria in kidney
Acute renal failure; Hb and breakdown products accumulate faster than liver clearance; hypovolemia; Blackwater fever
What is blackwater fever
Dark urine with severe fever, jaundice and vomiting
What counts as malaria infection
Hyperparasitemia; >2% for low transmission area and >5% in high transmission area
P falciparum characteristic (clinical disease, intra-erythrocytic cycle, sequestration, parasitemia)
Severe; 43-52 hrs; sequestration; high and commonly infect cells
P vivax characteristic (intra-erythrocytic cycle, hypnozoite stage, infected RBC, )
48 hrs; hypnozoite stage; infects reticulocytes
P malariae intra-erythrocytic cycle
72 hrs
P ovale characteristic (intra-erythrocytic cycle, hypnozoite stage)
48 hrs; hypnozoite stage
Which plasmodium have hypnozoite stages
P vivax and P ovale
What is P falciparum
Main cause of mortality; cerebral malaria; recrudescence, high parasitemia, only RINGS and GAMTETOCYTES

P falciparum ring stage
P falciparum gametocyte

(left)
P falciparum rings with Maurer’s cleft (dot)
CNS malaria
Cerebral from P falciparum and Mild cerebral from other plasmodium species
What is P vivax
Only colonize duffy blood group ag; Latent = hypnozoite stage; normal to enlarged RBC; Schuffner’s dots

P vivax ameboid trophozoite

Dots are schuffner’s dots
What is P ovale
Hypnozoite in liver = long lasting latent infection; ONLY in reticulocytes; low parasitemia; James’ dots

P ovale ring form

Trophozoite with James’ dot
What is P malariae
Latent infection; low parasitemia; merozoites invade OLDER RBC
P malariae ring form

P malariae with ziemann’s dot

P malariae schizont

P malariae trophozoite
What is P knowlesi
Zoonotic species; Malaysia and Indonesia; Fatal infection; invade RBC with duffy group
Malaria in pregnancy
hypoglycemia and pulmonary edema; parasitemia peaks in second trimester
What mosquito species carry filariasis causing parasite
Culex, Aedes, Anopheles, Mansonia
What are two important causes of lymphatic filariasis
Wucheria bancrofti, Brugia malayi
What is lymphatic filariasis
Cause lymphatic damage and dysfunction → Lead to elephantiasis and hydroceles
What is the main cause of elephantiasis and hydroceles
W. bancrofti
What is acute filarial lymphangitis
Inflammation of lymphatic vessel
What is acute dermato-lymphangioadenitis
Bacterial infection of small collecting lymphatic vessels